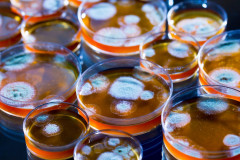

Lifestyle
 Ժամանակին նուրբ ու բնական Մարինկա Խաչատրյանը հիմա քառասուննանց կնոջ է հիշեցնում
Ժամանակին նուրբ ու բնական Մարինկա Խաչատրյանը հիմա քառասուննանց կնոջ է հիշեցնում
 Պլաստիկայի զոհը. Ահա, թե ինչպիսի գեղեցկուհի էր այս աղջիկը մինչ պլաստիկ վիրահատու...
Պլաստիկայի զոհը. Ահա, թե ինչպիսի գեղեցկուհի էր այս աղջիկը մինչ պլաստիկ վիրահատու...
 Սա իմանալուց հետո այլևս երբեք դեն չեք նետի բանանի կեղևը…
Սա իմանալուց հետո այլևս երբեք դեն չեք նետի բանանի կեղևը…
 Հնարավո՞ր է, արդյոք, ապրել առանց գլխի. պարզվում է՝ այո
Հնարավո՞ր է, արդյոք, ապրել առանց գլխի. պարզվում է՝ այո
 Տաթևիկ Ադումյանը հրաժարվել է 40-ամյա կնոջ կերպարից և դարձել շատ նուրբ ու կանացի
Տաթևիկ Ադումյանը հրաժարվել է 40-ամյա կնոջ կերպարից և դարձել շատ նուրբ ու կանացի
 ԹԵՍՏ. Ուզու՞մ եք ավելի լավը դարձնել ձեր կյանքը. Ընտրե՛ք սիմվոլն ու կիմանաք՝ ինչպես
ԹԵՍՏ. Ուզու՞մ եք ավելի լավը դարձնել ձեր կյանքը. Ընտրե՛ք սիմվոլն ու կիմանաք՝ ինչպես
 Հորոսկոպի 3 կանայք, ում առաջ աշխարհը պատրաստ է ծնկի գալ
Հորոսկոպի 3 կանայք, ում առաջ աշխարհը պատրաստ է ծնկի գալ
 Այս գարնան 5 ամենանորաձև կարճ զգեստները
Այս գարնան 5 ամենանորաձև կարճ զգեստները
 Հռիփսիմե Հակոբյանը տանն ավելի ճաշակով է հագնվում, քան դրսում
Հռիփսիմե Հակոբյանը տանն ավելի ճաշակով է հագնվում, քան դրսում
 Անտեսանելի ռազմական տեխնիկա. իրո՞ք տեսնել հնարավոր չէ
Անտեսանելի ռազմական տեխնիկա. իրո՞ք տեսնել հնարավոր չէ
 Կարո՞ղ եք գուշակել, թե «Էլենի օրագրի» ո՞ր գեղեցկուհին է այս հրաշք փոքրիկը
Կարո՞ղ եք գուշակել, թե «Էլենի օրագրի» ո՞ր գեղեցկուհին է այս հրաշք փոքրիկը
 Օրվա բաղադրատոմս. Կարտոֆիլը արքայական ձևով
Օրվա բաղադրատոմս. Կարտոֆիլը արքայական ձևով
 Ֆրանսիայում շոկոլադե տուն են կառուցել (Photo)
Ֆրանսիայում շոկոլադե տուն են կառուցել (Photo)
 Աշխարհի ամենագեղեցիկ գրադարանները՝ մեկ երկնքի տակ. գրադարաններ, որոնք իրական ժառ...
Աշխարհի ամենագեղեցիկ գրադարանները՝ մեկ երկնքի տակ. գրադարաններ, որոնք իրական ժառ...
 Այրվածքներով հոսպիտալացված 12-ամյա աղջկան ոչ մի հարազատ չի այցելել
Այրվածքներով հոսպիտալացված 12-ամյա աղջկան ոչ մի հարազատ չի այցելել
 Խոշոր վթար Երևան-Արմավիր ճանապարհին. վարորդը հիվանդանոցում է (ֆոտո)
Խոշոր վթար Երևան-Արմավիր ճանապարհին. վարորդը հիվանդանոցում է (ֆոտո)
 Հայկական շոու բիզնեսի Top 10 բիզնես լեդիները. Նրանք միշտ առաջատար են
Հայկական շոու բիզնեսի Top 10 բիզնես լեդիները. Նրանք միշտ առաջատար են
 Հայտնիների քույր-եղբայրներ, որոնց ոչ ոք դեռ չի տեսել
Հայտնիների քույր-եղբայրներ, որոնց ոչ ոք դեռ չի տեսել
 Լիլի Մորտոն ցուցադրել է, թե ինչ նուրբ ու համեստ կերպարով է շրջում Հայաստանից դուրս
Լիլի Մորտոն ցուցադրել է, թե ինչ նուրբ ու համեստ կերպարով է շրջում Հայաստանից դուրս
 Հայտնի ամենագեղեցիկ զույգերը. Այն, ինչ կցանկանային բոլորը
Հայտնի ամենագեղեցիկ զույգերը. Այն, ինչ կցանկանային բոլորը
 Այս տատիկին ծեծի էին ենթարկել օդանավակայանում. Ո՛չ ոստիկանները և ո՛չ էլ բժիշկներ...
Այս տատիկին ծեծի էին ենթարկել օդանավակայանում. Ո՛չ ոստիկանները և ո՛չ էլ բժիշկներ...
 Աննա Դովլաթյանը ցուցադրել է, թե ինչ շքեղ տեսքով է հանդես եկել «Ա.Կ.Ա.» ֆիլմի պրե...
Աննա Դովլաթյանը ցուցադրել է, թե ինչ շքեղ տեսքով է հանդես եկել «Ա.Կ.Ա.» ֆիլմի պրե...
 2019-ի ամենանուրբ ու նորաձև հարսանեկան զգեստները (ֆոտոշարք)
2019-ի ամենանուրբ ու նորաձև հարսանեկան զգեստները (ֆոտոշարք)
 Աղջիկը 17 տարեկանում հղիացել էր,ծնողները չգիտեին այդ մասին. Մի օր ապագա երեխայի ...
Աղջիկը 17 տարեկանում հղիացել էր,ծնողները չգիտեին այդ մասին. Մի օր ապագա երեխայի ...
 Սխտորը կարող է ոչնչացնել քաղցկեղի 14 և վարակի 13 տեսակ. Ինչու՞ բժիշկները դուրս չ...
Սխտորը կարող է ոչնչացնել քաղցկեղի 14 և վարակի 13 տեսակ. Ինչու՞ բժիշկները դուրս չ...
 Ով է աստղակերպի նշաններից ամենաառատաձեռնը և բարին!!Միշտ հասնում է օգնության
Ով է աստղակերպի նշաններից ամենաառատաձեռնը և բարին!!Միշտ հասնում է օգնության
 Սովորական ճակնդեղը մաքրում է լյարդը փոշեկուլի նման. Ինչի հետ է խորհուրդ տրվում ա...
Սովորական ճակնդեղը մաքրում է լյարդը փոշեկուլի նման. Ինչի հետ է խորհուրդ տրվում ա...
 Մոռացեք վարիկոզային քսուկների,հիշողության կորստի,գլխացավերի մասին այս տերևների շ...
Մոռացեք վարիկոզային քսուկների,հիշողության կորստի,գլխացավերի մասին այս տերևների շ...
 Այս էժան միջոցը ուղղակի մի ամբողջ գեղեցկության սրահ է. Ինչու՞ ես այս մասին չգիտեի
Այս էժան միջոցը ուղղակի մի ամբողջ գեղեցկության սրահ է. Ինչու՞ ես այս մասին չգիտեի
 Ի՞նչ կապ ունի «Առողջ մարմնում առողջ հոգի» կարգախոսը առողջության հետ
Ի՞նչ կապ ունի «Առողջ մարմնում առողջ հոգի» կարգախոսը առողջության հետ
 Եղվարդ-Աշտարակ ճանապարհին «Renault» կցորդիչով բեռնատարում հրդեհ է բռնկվել
Եղվարդ-Աշտարակ ճանապարհին «Renault» կցորդիչով բեռնատարում հրդեհ է բռնկվել Փաշինյանը կարևորել է Թուրքիայի և Ադրբեջանի հետ էլեկտրահաղորդման գծերի և կապակցիչների կառուցումը
Փաշինյանը կարևորել է Թուրքիայի և Ադրբեջանի հետ էլեկտրահաղորդման գծերի և կապակցիչների կառուցումը Իրավապահները 59-ամյա տղամարդու բակում հայտնաբերել են մշակված կանեփի 107 թուփ, նաև՝ 70 գրամ մարիխուանա
Իրավապահները 59-ամյա տղամարդու բակում հայտնաբերել են մշակված կանեփի 107 թուփ, նաև՝ 70 գրամ մարիխուանա  Ռուսաստանը կշարունակի nւժեղացնել ճնշnւմը կիևյան ռեժիմի վրա. Պեսկով
Ռուսաստանը կշարունակի nւժեղացնել ճնշnւմը կիևյան ռեժիմի վրա. Պեսկով
 Բացառում եմ 2013 թվականի իրավիճակը, երբ Հայաստանը մեկ գիշերում հրաժարվեց ԵՄ հետ ասոցացման գործընթացից ու գնաց ԵԱՏՄ․ Փաշինյան
Բացառում եմ 2013 թվականի իրավիճակը, երբ Հայաստանը մեկ գիշերում հրաժարվեց ԵՄ հետ ասոցացման գործընթացից ու գնաց ԵԱՏՄ․ Փաշինյան «Տոտենհեմը» իրականացրեց ակումբի պատմության ամենաթանկարժեք տրանսֆերը. պաշտոնական
«Տոտենհեմը» իրականացրեց ակումբի պատմության ամենաթանկարժեք տրանսֆերը. պաշտոնական Քիմ Քարդաշյանը ապացուցում է, որ ընձառյուծի նախշերը և միկրոստրինգները դեռևս թրենդային են
Քիմ Քարդաշյանը ապացուցում է, որ ընձառյուծի նախշերը և միկրոստրինգները դեռևս թրենդային են  Հայաստանի հանքարդյունաբերության և մետալուրգիայի ասոցիացիան ընդլայնում է գործունեությունը և համագործակցությունը
Հայաստանի հանքարդյունաբերության և մետալուրգիայի ասոցիացիան ընդլայնում է գործունեությունը և համագործակցությունը Թաիլանդում ավտոմեքենայի վրшերթի հետևանքով ութ բուդդայական վանական է զnhվել
Թաիլանդում ավտոմեքենայի վրшերթի հետևանքով ութ բուդդայական վանական է զnhվել
 Հայաստանը դեռևս բախվում է նշանակալի տնտեսական ճնշման Ռուսաստանի կողմից, կարող ենք վերաուղղորդել այն արտադրանքները, որոնք այժմ մեծապես ուղղված են ռուսական շուկա, և դրանք ուղարկել ԵՄ միասնական շուկա. ֆոն դեր Լայեն
Հայաստանը դեռևս բախվում է նշանակալի տնտեսական ճնշման Ռուսաստանի կողմից, կարող ենք վերաուղղորդել այն արտադրանքները, որոնք այժմ մեծապես ուղղված են ռուսական շուկա, և դրանք ուղարկել ԵՄ միասնական շուկա. ֆոն դեր Լայեն Եռօրյա ֆինանսական գրագիտության դասընթաց` Fast հիմնադրամի AI Camp ճամբարում․ Idram&IDBank
Եռօրյա ֆինանսական գրագիտության դասընթաց` Fast հիմնադրամի AI Camp ճամբարում․ Idram&IDBank Վաղը Կիևում հայտարարված է uգn օր՝ ի հիշատակ մայրաքաղաքի վրա ՌԴ-ի hարձակման զnhերի. Կիևի քաղաքապետ
Վաղը Կիևում հայտարարված է uգn օր՝ ի հիշատակ մայրաքաղաքի վրա ՌԴ-ի hարձակման զnhերի. Կիևի քաղաքապետ ՆԳՆ քրեական ոստիկանները վնասազերծել են խոշոր չափերի համակարգչային հափշտակություններ իրականացնող խմբի
ՆԳՆ քրեական ոստիկանները վնասազերծել են խոշոր չափերի համակարգչային հափշտակություններ իրականացնող խմբի Ռուսաստանի տարածքում 327 ուկրաինական ԱԹՍ է խnցվել. ՌԴ ՊՆ
Ռուսաստանի տարածքում 327 ուկրաինական ԱԹՍ է խnցվել. ՌԴ ՊՆ
 Իրավապահները վերածվել էին իշխանության քարոզիչների․ Ցոլակ Ակոպյան
Իրավապահները վերածվել էին իշխանության քարոզիչների․ Ցոլակ Ակոպյան  Անվավեր ճանաչվեցին միայն «անհարմար» տեղամասերի արդյունքները․ Ատոմ Մխիթարյան
Անվավեր ճանաչվեցին միայն «անհարմար» տեղամասերի արդյունքները․ Ատոմ Մխիթարյան Քրեակատարողականի աշխատակցի պարտականությունը կալանավորին ծեծելը չի․ Արշակ Կարապետյան
Քրեակատարողականի աշխատակցի պարտականությունը կալանավորին ծեծելը չի․ Արշակ Կարապետյան
 Թուրքիան ՀՀ Ազգային ժողովի նախագահ նշանակել է Ռուբեն բեյ Ռուբինյանին․ Շիրազ Մանուկյան
Թուրքիան ՀՀ Ազգային ժողովի նախագահ նշանակել է Ռուբեն բեյ Ռուբինյանին․ Շիրազ Մանուկյան Արտեմ Սարգսյանի աջակցությամբ ԱՄՆ-ի Մարտարվեստի պատմության թանգարանում բացվել է հայկական մշտական ցուցադրություն (տեսանյութ)
Արտեմ Սարգսյանի աջակցությամբ ԱՄՆ-ի Մարտարվեստի պատմության թանգարանում բացվել է հայկական մշտական ցուցադրություն (տեսանյութ)
 Կապանը կրկին կդառնա դասական երաժշտության միջազգային մայրաքաղաքը. մեկնարկում է Կապան Ֆեստը
Կապանը կրկին կդառնա դասական երաժշտության միջազգային մայրաքաղաքը. մեկնարկում է Կապան Ֆեստը
 Եթե էս հերոսներին կարելի է այսպես վերաբերվել, եթե մենք շարունակելու ենք լուռ նստել մեր տներում, ապա վաղվա դատարկված Հայաստանի համար ոչ ոքի չմեղադրեք․ Աննա Ղուկասյան
Եթե էս հերոսներին կարելի է այսպես վերաբերվել, եթե մենք շարունակելու ենք լուռ նստել մեր տներում, ապա վաղվա դատարկված Հայաստանի համար ոչ ոքի չմեղադրեք․ Աննա Ղուկասյան Ժողովրդավար Եվրոպայի առաջնորդներն էլ չկարողացան օգնել Փաշինյանին` հավաքել ձայների 3/5-ը. Արմեն Մանվելյան
Ժողովրդավար Եվրոպայի առաջնորդներն էլ չկարողացան օգնել Փաշինյանին` հավաքել ձայների 3/5-ը. Արմեն Մանվելյան Ազատ խոսքը, որի պատճառով այսօր նստած են այս մարդիկ, ունիվերսալ արժեք է․ Մենուա Սողոմոնյան
Ազատ խոսքը, որի պատճառով այսօր նստած են այս մարդիկ, ունիվերսալ արժեք է․ Մենուա Սողոմոնյան Այս ընտրությունները չեն եղել Սահմանադրության 7-րդ հոդվածի համապատասխան․ Արամ Վարդևանյան
Այս ընտրությունները չեն եղել Սահմանադրության 7-րդ հոդվածի համապատասխան․ Արամ Վարդևանյան Հարևան երկրին պետք էր իրենց ներկայացուցիչը Ազգային ժողովում․ Նարեկ Կարապետյան
Հարևան երկրին պետք էր իրենց ներկայացուցիչը Ազգային ժողովում․ Նարեկ Կարապետյան Դադարեցրե’ք դարձնել ժողովրդավարությունն ընտրովի. Կոստանյանն ընթերցեց «ՀայաՔվե»-ի նամակը Եվրահանձնաժողովի նախագահին
Դադարեցրե’ք դարձնել ժողովրդավարությունն ընտրովի. Կոստանյանն ընթերցեց «ՀայաՔվե»-ի նամակը Եվրահանձնաժողովի նախագահին
 Մեծ պատիվ էր հերթական անգամ հանդիպել մեր հերոսներին․ Մհեր Ավետիսյան
Մեծ պատիվ էր հերթական անգամ հանդիպել մեր հերոսներին․ Մհեր Ավետիսյան Արևային էներգիան Չինաստանի Տակլամական անապատը վերածում է կանաչ միջանցքի
Արևային էներգիան Չինաստանի Տակլամական անապատը վերածում է կանաչ միջանցքի
 Ֆասթ Բանկի աջակցությամբ մեկնարկել է «Հուսո առագաստ» հեղինակային երգի փառատոնը
Ֆասթ Բանկի աջակցությամբ մեկնարկել է «Հուսո առագաստ» հեղինակային երգի փառատոնը
 Սուրճ, ընդմիջում և մինչև 10% idcoin. Idram&IDBank
Սուրճ, ընդմիջում և մինչև 10% idcoin. Idram&IDBank
 GTB Development ընկերությունը դարձել է Հայաստանի պետական սիմֆոնիկ նվագախմբի 21-րդ համերգաշրջանի գլխավոր գործընկերը
GTB Development ընկերությունը դարձել է Հայաստանի պետական սիմֆոնիկ նվագախմբի 21-րդ համերգաշրջանի գլխավոր գործընկերը «ՀայաՔվեի» և «Մայր Հայաստանի» բողոքի ակցիան` ի պաշտպանություն քաղբանտարկյալների
«ՀայաՔվեի» և «Մայր Հայաստանի» բողոքի ակցիան` ի պաշտպանություն քաղբանտարկյալների Որևէ պարագայում Արցախի նախագահը չպիտի հրաժարական տար․ Էդմոն Մարուքյան
Որևէ պարագայում Արցախի նախագահը չպիտի հրաժարական տար․ Էդմոն Մարուքյան Ուշադրություն. Փաշինյանը միտումնավոր երկարաձգել է նպաստների կրճատման մասին որոշումը
Ուշադրություն. Փաշինյանը միտումնավոր երկարաձգել է նպաստների կրճատման մասին որոշումը
 Եթե մեր երկրում համատարած կոռուցիա է, ուրեմն երկրի ղեկավարը իր ճիշտ տեղում չէ. Արամ Պետրոսյան
Եթե մեր երկրում համատարած կոռուցիա է, ուրեմն երկրի ղեկավարը իր ճիշտ տեղում չէ. Արամ Պետրոսյան Աբաջյանի և Ուրֆանյանի դիրքը հետ բերող զինվորականին՝ Էդիկ Մալոյանին, ձերբակալել են. Նարեկ Կարապետյան
Աբաջյանի և Ուրֆանյանի դիրքը հետ բերող զինվորականին՝ Էդիկ Մալոյանին, ձերբակալել են. Նարեկ Կարապետյան
 Ավետիք Չալաբյանի ահա այս սկզբունքային դիրքորոշման համար է վարչախումբը բանտարկել նրան
Ավետիք Չալաբյանի ահա այս սկզբունքային դիրքորոշման համար է վարչախումբը բանտարկել նրան «ՀայաՔվեի» երթը դեպի կառավարության շենք` քաղբանտարկյալների ազատ արձակման պահանջով
«ՀայաՔվեի» երթը դեպի կառավարության շենք` քաղբանտարկյալների ազատ արձակման պահանջով Ucom-ը ներկայացնում է նոր uMix 5000 մարզային փաթեթը․ 3 ծառայություն՝ ընդամենը 5000 դրամ ամսավճարով
Ucom-ը ներկայացնում է նոր uMix 5000 մարզային փաթեթը․ 3 ծառայություն՝ ընդամենը 5000 դրամ ամսավճարով
 Ե՞րբ և ինչպե՞ս որոշվեց ինքնաթիռներում սնունդ տալ ուղևորներին. «Փաստ»
Ե՞րբ և ինչպե՞ս որոշվեց ինքնաթիռներում սնունդ տալ ուղևորներին. «Փաստ» Toyota-ն երկրորդ պաշտոնական ավտոսրահն է բացում Երևանում. հայտնի է մրցույթի հաղթողը
Toyota-ն երկրորդ պաշտոնական ավտոսրահն է բացում Երևանում. հայտնի է մրցույթի հաղթողը
 ՊԱՏՄՈՒԹՅԱՆ ԱՅՍ ՕՐԸ (2 հուլիսի). Ասիական ֆինանսական ճգնաժամը, օդապարիկով առաջին շուրջերկրյա ճանապարհորդությունը. «Փաստ»
ՊԱՏՄՈՒԹՅԱՆ ԱՅՍ ՕՐԸ (2 հուլիսի). Ասիական ֆինանսական ճգնաժամը, օդապարիկով առաջին շուրջերկրյա ճանապարհորդությունը. «Փաստ» Էկոնոմիկան պետք է անջատել քաղաքականությունից. Արշակ Կարապետյան
Էկոնոմիկան պետք է անջատել քաղաքականությունից. Արշակ Կարապետյան
 ՕՊԵԿ-ը կանգնած է ռազմավարական ընտրության առաջ. «Փաստ»
ՕՊԵԿ-ը կանգնած է ռազմավարական ընտրության առաջ. «Փաստ» Ընտրախախտումները եղել են զանգվածային, եղել են համակարգային և բավարար են, որպեսզի Սահմանադրական դատարանը ԿԸՀ ընդունած որոշումը ճանաչի անվավեր․ Վարդևանյան
Ընտրախախտումները եղել են զանգվածային, եղել են համակարգային և բավարար են, որպեսզի Սահմանադրական դատարանը ԿԸՀ ընդունած որոշումը ճանաչի անվավեր․ Վարդևանյան  «Սյունյաց երկրի» մաղթանքը Գևորգ Փարսյանին՝ այդ շենքից համայնքը ղեկավարել ևս մի քանի ընտրաշրջան
«Սյունյաց երկրի» մաղթանքը Գևորգ Փարսյանին՝ այդ շենքից համայնքը ղեկավարել ևս մի քանի ընտրաշրջան
 Մինչ խոսվում է վիզաների ազատականացման մասին, հայաստանցիների համար գնալով ավելի դժվար է դառնում Շենգենյան վիզա ստանալը. «Փաստ»
Մինչ խոսվում է վիզաների ազատականացման մասին, հայաստանցիների համար գնալով ավելի դժվար է դառնում Շենգենյան վիզա ստանալը. «Փաստ» ՔՊ-ն ընտրություններով չստացավ ցանկալի արդյունքը, հիմա անցել է ահաբեկման․ Արեգ Սավգուլյան
ՔՊ-ն ընտրություններով չստացավ ցանկալի արդյունքը, հիմա անցել է ահաբեկման․ Արեգ Սավգուլյան Դասական բլեֆ. ի՞նչ ընտրություն է կատարելու Ռուսաստանը. «Փաստ»
Դասական բլեֆ. ի՞նչ ընտրություն է կատարելու Ռուսաստանը. «Փաստ» «Տղայիս վերջին խոսքերն էին՝ ուժեղ մնա, մա՛մ». Արարատ Մինասյանն անմահացել է սեպտեմբերի 28-ին Թալիշում, տուն «վերադարձել»... չորս ամիս անց. «Փաստ»
«Տղայիս վերջին խոսքերն էին՝ ուժեղ մնա, մա՛մ». Արարատ Մինասյանն անմահացել է սեպտեմբերի 28-ին Թալիշում, տուն «վերադարձել»... չորս ամիս անց. «Փաստ» 
 Թուրքիան ՀՀ Ազգային ժողովի նախագահ նշանակել է Ռուբեն բեյ Ռուբինյանին․ Շիրազ Մանուկյան
Թուրքիան ՀՀ Ազգային ժողովի նախագահ նշանակել է Ռուբեն բեյ Ռուբինյանին․ Շիրազ Մանուկյան
 Եթե էս հերոսներին կարելի է այսպես վերաբերվել, եթե մենք շարունակելու ենք լուռ նստել մեր տներում, ապա վաղվա դատարկված Հայաստանի համար ոչ ոքի չմեղադրեք․ Աննա Ղուկասյան
Եթե էս հերոսներին կարելի է այսպես վերաբերվել, եթե մենք շարունակելու ենք լուռ նստել մեր տներում, ապա վաղվա դատարկված Հայաստանի համար ոչ ոքի չմեղադրեք․ Աննա Ղուկասյան
 Ազատ խոսքը, որի պատճառով այսօր նստած են այս մարդիկ, ունիվերսալ արժեք է․ Մենուա Սողոմոնյան
Ազատ խոսքը, որի պատճառով այսօր նստած են այս մարդիկ, ունիվերսալ արժեք է․ Մենուա Սողոմոնյան
 Մեծ պատիվ էր հերթական անգամ հանդիպել մեր հերոսներին․ Մհեր Ավետիսյան
Մեծ պատիվ էր հերթական անգամ հանդիպել մեր հերոսներին․ Մհեր Ավետիսյան
 «ՀայաՔվեի» և «Մայր Հայաստանի» բողոքի ակցիան` ի պաշտպանություն քաղբանտարկյալների
«ՀայաՔվեի» և «Մայր Հայաստանի» բողոքի ակցիան` ի պաշտպանություն քաղբանտարկյալների